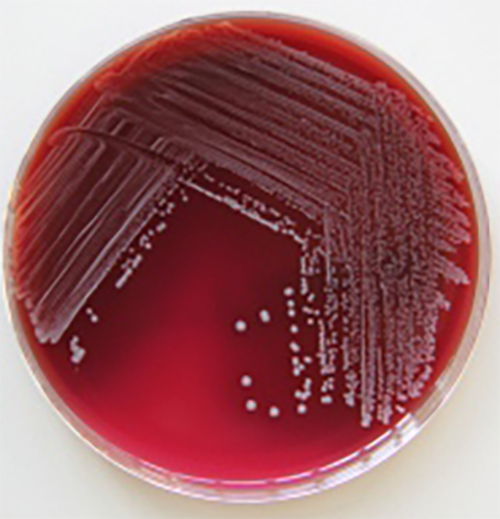

Коринебактерии Corynebacterium SPP: микроскопическая красота природы


























.jpg/9deee27c-4008-a385-7fc3-860a77b2dce9?t=1650280632372)


































:quality(90)/images.vogel.de/vogelonline/bdb/1024300/1024349/original.jpg)

Раздел: Другие животные